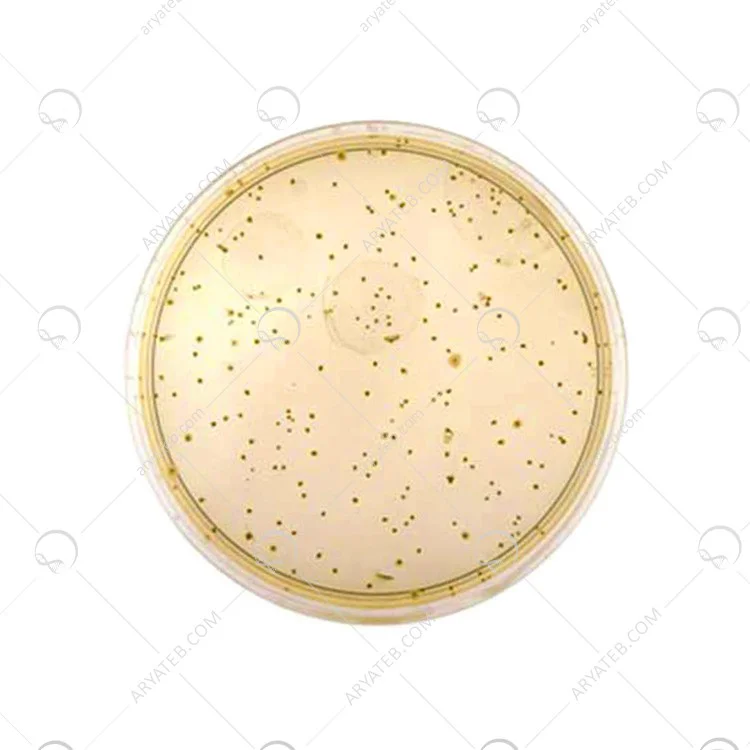

محیط کشت رینفورس کلاستریدیال آگار
- محیط کلستریدیال تقویت شده حاوی پپتون و گوشت گاو است
- استخراج شده از محیط کلستریدیال تقویت شده به عنوان منبع کربن، نیتروژن، ویتامین ها و مواد معدنی.
- محیط RCM باعث رشد باکتریایی منبع کربوهیدرات و دکستروز می شود.
محیط کشت RCM
محیط کشت رینفورس کلاستریدیال آگار (Reinforced Clostridial Agar)
محیط کشت رینفورس کلاستریدیال آگار، یا به اختصار RCA، یک محیط کشت غنی شده و انتخابی است که برای جداسازی و کشت انواع مختلف باکتریهای کلستریدیوم طراحی شده است. این باکتریها به دلیل توانایی رشد در شرایط بیهوازی و تولید اسپور، جداسازی آنها از نمونههای بالینی اغلب چالشبرانگیز است. محیط کشت RCA با فراهم کردن شرایط مناسب رشد و مهار رشد سایر باکتریها، این فرآیند را تسهیل میکند.
ترکیبات
-
پپتون: منبع نیتروژن، اسیدهای آمینه و سایر مواد مغذی ضروری برای رشد باکتریها.
-
عصاره گوشت: منبع ویتامینها، مواد معدنی و عوامل رشد برای باکتریها.
-
گلوکز: منبع انرژی برای باکتریها.
-
آگار: عامل جامد کننده محیط کشت.
-
تیوگلیکولات سدیم: عامل احیا کننده که محیط کشت را بیهوازی میکند و به رشد باکتریهای بیهوازی کمک میکند.
-
بی کربنات سدیم: با تولید دی اکسید کربن، محیط کشت را اسیدی کرده و شرایط رشد بهینه برای کلستریدیومها را فراهم میکند.
کاربردها
-
جداسازی کلستریدیومها از نمونههای بالینی: از جمله مدفوع، زخم، بافت و مواد غذایی.
-
شمارش کلستریدیومها در نمونههای محیطی: مانند خاک و آب.
-
تستهای حساسیت به آنتیبیوتیکها: برای تعیین الگوی حساسیت باکتریهای کلستریدیوم به آنتیبیوتیکها.
-
مطالعات اپیدمیولوژیک: برای بررسی شیوع عفونتهای ناشی از کلستریدیوم.
روش تهیه
توزین: مقدار مشخصی از پودر محیط کشت RCA را در آب مقطر اندازه گیری شده بریزید.
-
حل کردن: مخلوط را به آرامی حرارت دهید تا پودر محیط کشت به طور کامل حل شود.
-
اتوکلاو کردن: محیط کشت را در اتوکلاو در دمای 121 درجه سانتیگراد به مدت 15 دقیقه استریل کنید.
-
ریختن در پلیت: محیط کشت استریل شده را به آرامی در پلیتهای پتری استریل بریزید و اجازه دهید تا سرد و جامد شود.
روش کشت
-
تهیه نمونه: نمونه بالینی را به صورت استریل جمعآوری کنید.
-
کشت: نمونه را بر روی سطح محیط کشت RCA کشت دهید.
-
انکوباسیون: پلیتهای کشت را در شرایط بیهوازی (به طور مثال، در یک جار بیهوازی یا با استفاده از گازهای بیاثر) و دمای 35-37 درجه سانتیگراد به مدت 18-24 ساعت انکوبه کنید.
مشاهده و تفسیر نتایج
کلنیهای کلستریدیوم معمولاً بزرگ، گرد و سفید یا خاکستری هستند. برخی گونهها ممکن است کلنیهای همولیتیک ایجاد کنند. برای شناسایی دقیق گونههای کلستریدیوم، تستهای بیوشیمیایی و مولکولی بیشتری لازم است.
نکات مهم
-
محیط کشت RCA باید به صورت بیهوازی انکوبه شود.
-
برای اطمینان از کیفیت محیط کشت، از کنترل مثبت (یک سویه استاندارد کلستریدیوم) و کنترل منفی (یک محیط کشت استریل) استفاده کنید.
-
برای جداسازی گونههای خاص کلستریدیوم، ممکن است نیاز به استفاده از محیطهای کشت تخصصیتر باشد.
ترکیبات محیط کشت Reinforced clostridial medium
.jpg)
ملاحظات ایمنی:
-
هنگام کار با نمونههای بالینی و محیطهای کشت، از تجهیزات حفاظتی مناسب استفاده کنید.
-
از اتوکلاو برای استریل کردن محیط کشت و تجهیزات استفاده کنید.
-
از روشهای مناسب برای دفع زبالههای عفونی استفاده کنید.
در کل، محیط کشت رینفورس کلاستریدیال آگار یک ابزار ارزشمند برای جداسازی و شناسایی باکتریهای کلستریدیوم است. با رعایت نکات ایمنی و فنی، میتوان از این محیط کشت برای تشخیص دقیق عفونتهای ناشی از این باکتریها استفاده کرد.
برای دیدن سایر مواد آزمایشگاهی کلیک کنید
آدرس ایمیل شما منتشر نخواهد شد. فیلدهای الزامی علامت گذاری شده اند *